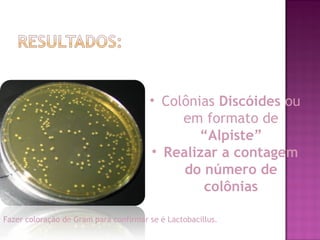
• Colônias Discóides ou
em formato de
“Alpiste”
• Realizar a contagem
do número de
colônias
Fazer coloração de Gram para confirmar se é Lactobacillus.

O documento descreve o procedimento para isolar e contar Lactobacillus presentes na saliva para avaliar o risco de agravamento da doença cárie no indivíduo. O procedimento envolve a coleta de saliva, diluições seriadas, semeadura em placa de Petri contendo ágar seletivo para Lactobacillus, incubação e contagem de colônias para estimar o número de Lactobacillus e associar ao risco de cárie.